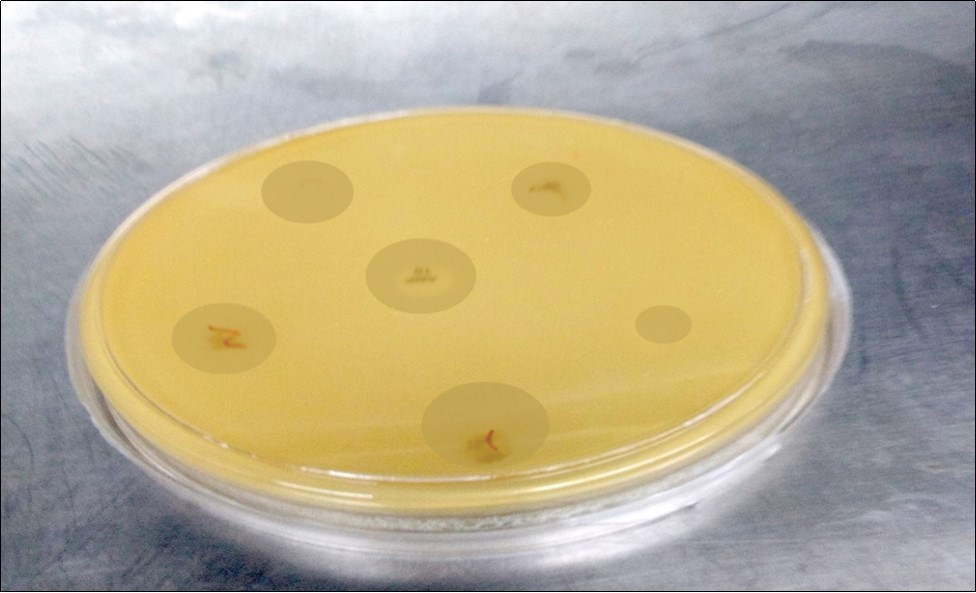

Abstract
The solid copper(II) soap derived from Neem (Azadirechta Indica)oil and its complex with ligand containing nitrogen, sulphur and oxygen atoms like 2-amino -6-nitro benzothiazole and 2-amino- 6-ethoxy benzothiazole have been synthesized and characterised by elemental analysis, IR spectroscopy and biological studies. From the analytical data, the stoichiometry of the complex has been observed to be 1:1 (metal:ligand). The derived compounds were found active against Staphylococcus aureus,Coagulase-negative staphylococci (CoNs), Acinetobacter baumanii, Pseudomonas aeruginosa and micrococcus bacteria. These findings have high medical, industrial and economic significance as copper (II) soap and copper (II) soap complex could be harnessed in the formulation of medicated soaps.
Author Contributions
Academic Editor: Dina S El-Agamy, Dept. of Pharmacology& Toxicology College of Pharmacy Taibah University, Almadinah Almunawarrah, KSA Mansoura University, Mansoura, Egypt.
Checked for plagiarism: Yes
Review by: Single-blind
Copyright © 2018 Priyanka Kumawat, et al.
 This is an open-access article distributed under the terms of the Creative Commons Attribution License, which permits unrestricted use, distribution, and reproduction in any medium, provided the original author and source are credited.
This is an open-access article distributed under the terms of the Creative Commons Attribution License, which permits unrestricted use, distribution, and reproduction in any medium, provided the original author and source are credited.
Competing interests
The authors have declared that no competing interests exist.
Citation:
Introduction
The current global attention towards the production of biodiesel especially from non-edible sources has made research into production of non-edible vegetable oil a necessity. Biodiesel is a clean, biodegradable, non-toxic, renewable and environmentally friendly energy source made from fat and oil via transesterification processes. Neem (Azadirechta Indica) oil is generally light to dark brown, bitter and has a rather strong odour that is said to combine the odours of peanut and garlic. It comprises mainly triglycerides and large amounts of triterpenoid compounds, which are responsible for the bitter taste. It also contains azadirachtin, meliantriol, salannin, nimbin and nimbidin. 1, 2
Neem (Azadirechta Indica)oil is widely used as insecticides, lubricant, drugs for variety of diseases such as diabetes and tuberculosis. This oil could also prolong leather goods when it is applied on them. There are several methods to obtain neem (Azadirechta Indica)oil from the seeds like mechanical pressing, supercritical fluid extraction, and solvent extraction. Antiseptic soap, sometimes called anti-bacterial soap or anti-fungal soap, is a regular soap in liquid or solid form. According to Osbore and Grobe antibacterial soaps can remove 65 to 85% bacteria from human skin. Contemporary commercial antimicrobial soaps contain synthetic chemicals such as triclosan, triclorocarbanilide and chloroxylenol, most of which are thought to be car-cinogenic, mutagenic and or generate allergic reactions. 3, 4
Thiazole a heterocyclic nucleus played influential role in the advancement of different medicinally important moiety. They are mainly intrinsically toxic to microorganism especially to fungi and bacteria. Substituted benzothiazoles and phenylthiourea constitute an important class of compounds. The basic structure of benzothiazole consist of benzene ring fused with 4, 5 position of thiazole. Copper has efficiency to bind with fatty acids and oils to form copper soaps. Copper (II) soaps in polar and non polar solvents are used in emulsification, wetting, lubricating and foaming due to their surface active properties. Combination of copper soaps with heterocyclic ligands play wonderful role in various fields. They show fungicidal, pesticidal, insecticidal and nematocidal activities. The above mentioned applications give us the reason to synthesize the complexes of copper soap with N-donor ligands. With the help of elemental analysis, melting points IR spectroscopy; characterization of these complexes were done. 5, 6, 7
Micro-Organisms Taken for Study are as Follow
Micro-oraganisms employed to study and explain the bactericidal processes of complex synthesized in our laboratory were as follows:
Staphylococcus Aureus
S. aureus are cocci that form irregular grape-like clusters. They are non-motile, non-sporing and catalase positive. They grow rapidly and abundantly under aerobic conditions. On blood agar, they appear as glistening, smooth, entire, raised, translucent colonies that often have a golden pigment. 8
Coagulase Negative Staphylococci (CoNS)
Coagulase negative staphylococci (CoNS) are normal commensals of the skin, anterior nares, and ear canals of humans. They have long been considered as non-pathogenic, and were rarely reported to cause severe infections. However, as a result of the combination of increased use of intravascular devices and an increase in the number of hospitalized immunocompromised patients, CoNS have emerged as a major cause of nosocomial bloodstream infections. 9
Acinetobacter Baumanii
Acinetobacter species are Gram negative nonfermentative bacteria commonly present in soil and water as free living saprophytes. They are isolated as commensals from skin and throat. There have been frequent changes in their taxonomy so that their pathogenic role is understood only recently. Acinetobacter has emerged as an important nosocomial pathogen involved in outbreaks of hospital infections. 10
Pseudomonas Aeruginosa
Pseudomonas aeruginosa, a worldwide prevalent pathogen mainly associated to respiratory infections, is ubiquitous in nature, with the water as its preferred habitat. Hydropathic facilities, commonly named thermae, are used to treat respiratory health conditions by deep inhalation of unprocessed natural mineral water. 11
Micrococcus Luteus
They are mostly arranged in tetrads. They are positive for catalase and oxidase. They grow in circular, entire, convex and creamy yellow pigmented colonies having diameters of approximately 4mm after 2-3 days at 37°C. Several uncommon strains produce raised colonies with translucent, depressed centres. Colony pigmentation varies considerably but are usually different shades of yellow or cream-white. 12
Experimental
All the chemicals used were of LR/AR grade. Solvent was purified according to standard procedures before use. Elemental analysis was done for soap and complex for their metal content following standard procedures. The complexes under study were prepared in two steps. In the first step, copper soap was prepared and in the second step complexation of copper soap was done with ligands like nitro benzothaizole and ethoxy benzothaizole. 13
Benzene was dehydrated by storage over sodium wire for 2–3 days and by refluxing for about twenty hours, it was then distilled and redistillation was carried out azeotropically with ethanol. 14
Copper soap was prepared by refluxing the non edible oils i.e. Neem oil, in its pure form, of a available in the Indian market, with alcohol and 2N KOH solution for 3 hours (Direct metathesis). The neutralization of excess KOH present was done by 1N HCl. Saturated solution of copper sulphate was then added to it for conversion of neutralized soap into copper soap. Copper soap so obtained was then washed with hot water and dried. The soap was recrystallized using hot benzene. The fatty acid composition of the non edible oil was confirmed through gas liquid chromatography GLC of its methyl esters and is given in Table 1. 15
Table 1. Fatty acid composition of oil used for copper soap / complexes synthesis| Name of oil | % fatty acid | ||||
| 16:0 | 18:0 | 18:1 | 18:2 | Other acid (C20 – C24) | |
| Neem oil | 14.9 | 14.4 | 61.9 | 7.5 | 1.3 |
The ligands 2-amino -6-nitro benzothaizole and 2-amino -6-ethoxy benzothaizole were synthesized using thiocyanation method. The purified copper soap derived from non edible oil was refluxed with ligands (2-amino-6-nitro benzothaizole and 2-amino-6-ethoxy benzothaizole) in 1:1 ratio using benzene as a solvent for one hour. It was then filtered hot, dried, recrystallized and purified in hot benzene. Thin layer chromatography TLC using silica gel was used to check the purity of the complex.16
In general, all the soild complexes obtained were green in colour. The complexes were soluble in benzene and other organic solvents but insoluble in water. The complexes were stable at room temperature, their physical parameters like saponification value (S.V.), saponification equivalent (S.E.) and molecular weights are recorded in Table 2.
Table 2. Analytical and physical data of copper soap and their complexes derived from Neem oil| Name of soap/complexes | Colour | M.P. | Metal Content % | S.V. | S.E. | Average M.W. | |
| Observe | Calculate | ||||||
| CN | Dark Green | 500c | 10.16 | 10.07 | 198 | 283.33 | 628.16 |
| CNB | Green | 620c | 8.46 | 8.26 | - | - | 768.28 |
| CEB | Green | 600c | 8.46 | 8.27 | - | - | 767.34 |
IR spectral data for copper (II) Neem Soap and their Complexes
On the basis of the elemental analysis, 1:1 (metal:ligand) type of stoichiometry has been suggested.
Material & Methods
In order to study the structure of soap and complexes, the infra–red (IR) absorption spectra of compounds were obtained on a ABB Horizon MB 3000 series instrument spectrophotometer (4000 – 600 cm-1) from SPC Govt. College, Ajmer.
The biological activities of copper soap and its corresponding complex with ligand nitro and ethoxy benzothaizole have been screened against Staphylococcus aureus, Coagulase-negative staphylococci (CoNs), Acinetobacter baumanii, Pseudomonas aeruginosa, and micrococcus bacteria at 3 * 104 ppm, 1.5* 104 ppm, .75* 104 ppm, and .375 * 104 ppm using disc of these solutions by Mueller Hinton Agar plates.
The following Bacteria: Staphylococcus aureus, Pseudomonas aeruginosa, CoNS, Micrococcus and Acinetobactor. All bacterial strains were maintained on nutrient agar medium at ±37°C. These cultures are obtained from the Department of Microbiology, Dr. S.N. Medical College Jodhpur.
Antimicrobial Evaluation
The antimicrobial activity of newly synthesized compounds was evaluated using agar disc diffusion assay. Briefly, a 24 and 48 hours old culture of selected bacteria was mixed with sterile physiological saline (0.9%) and the turbidity was adjusted to the standard inoculum of Mac Farland scale 0.5 (106 colony forming units (CFU) per ml). Petri plates containing 20 ml of Mueller Hinton Agar was used for antibacterial activity. The inoculum was spread on the surface of the solidified media and Whatman No. 1 filter paper discs (5 mm in diameter) impregnated with the test compound (20 μl/disc) were placed on the plates. Ampicillin (10 mg/disc) was used as positive control for bacteria. A paper disc impregnated with petroleum ether was used as a negative control. Plates inoculated with the bacteria were incubated for 24 hour at 37° C. The inhibition zone diameters were measured in centimeters. All the tests were performed in triplicate, The E test (AB Biodisk) which is a quantitative method for antimicrobial susceptibility testing was applied the dilution of antibiotic and diffusion of antibiotic into the medium and the average was taken as final reading. A method is considered repeatable if independent repeats of the same experiment in the same laboratory produce nearly the same results. The conventional measure of repeatability is the standard deviation or some multiple of the standard deviation, standard error, variance etc.17, 18 The ANOVA (software) also provided a variance component analysis to assess the variance within experiments and the variance between experiments. The square root of the sum of those two variances was sr, which was interpreted as the typical difference, sign neglected, between the log density for a single (randomly chosen) experiment. 19
Results and Discussion
The copper soap and complexes are abbreviated as follows
a. Copper - Neem Soap (CN)
b. Copper – Neem Soap 2-amino -6-nitro Benzothaizole Complex (CNB)
c. Copper – Neem Soap 2-amino -6-ethoxy Benzothaizole Complex (CEB)
Figure 1.IR Spectra of Copper Neem Soap
IR Spectral Analysis
The absorption bands observed at 2924 cm-1 and 2854 cm–1 corresponds to asymmetric and symmetric stretching ofmethylene (-CH2) group. The presence of absorption bandsat 1458 cm–1 is representative of symmetric bending ofnearly 3010 cm–1 corresponds to olefinic =C–H stretch.The strong absorption band at 1589 cm–1 were due to carboxylate ion COO–,C–Oanti symmetric respectively. Also>C=O stretching bands were observed at 1744 cm–1. Also peaks corresponding to –CH3 and –CH2 rocking have been seen at 1157 cm–1 and 725 cm–1 respectively. Copper–oxygen (Cu–O) stretching bands have been distinguished at 424 cm–1. 20
The above-mentioned absorption bands (Table 3) were found to be common with the absorption bands observed for pure copper soap of non edible oils. Apart from these absorption bands the following bands were also observed corresponding to the ligand moiety. 21
Table 3. IR spectral data for copper (II) Neem Soap and their Complexes| Absorption bands | CN (cm-1) | CNB (cm-1) | CEB (cm-1) |
| Corresponding to soap moiety | |||
| Olefinic =C–H stretching | 3010 | 3010 | 3010 |
| CH3 and CH2, C–H Anti sym. stretching (vas) | 2916 | 2924 | 2924 |
| CH3 and CH2, C–H sym. stretching (vs) | 2854 | 2854 | 2854 |
| C=C Stretching | 2200 | 2152 | 2160 |
| >C=O Stretching | 1744 | 1744 | 1744 |
| C=C Stretching (Cis Unconjugated) | 1665 | 1651 | 1655 |
| COO -, C–O Anti-sym. stretching | 1582 | 1589 | 1582 |
| CH2, C–H Bending (δ) (scissoring) | 1465 | 1458 | 1458 |
| C–H, deformation, =C–H Rocking | 1443 | 1427 | 1420 |
| CH3, C–H Rocking | 1157 | 1157 | 1157 |
| CH2, C–H Rocking | 725 | 717 | 825 |
| =C-H, Out of Plane Bending of C-H | 679 | 648 | 725 |
| Cu–O stretching | 480 | 560 | 560 |
| Corresponding to ligand moiety | |||
| Asymm. NH2, N–H stretching | - | 3672 | 3742 |
| NH2, N–H stretching | - | 3564 | 3564 |
| C–N stretching | - | 2361 | 2361 |
| Unconjugated C–N stretching | - | 1095 | 1095 |
| C–H, deformation due to benzene (out of plane) | - | 648 | 649 |
The C–N stretching band of primary amide was observed at nearly 2361 cm–1 the absorptionband 1744 cm–1 was found to be representative of amide>C=O group. A broad band near 3564 cm–1 was observed corresponding to N–H stretching of amides. Also unconjugatedC-N stretching band was observed at1095 cm–1. C–H stretching band due to deformation out of plane (in benzene) was also observed at 649 cm–1. (Table 3) 22
Thus on the basis of above observations it can be safely assumed that complexation of copper soap has taken place with 2-amino -6-nitro benzothaizole and 2-amino -6-ethoxy benzothaizole.
Biological Activities
Neem soap ethoxy complex and Neem soap nitro complex show higher antibacterial activity than pure soap suggesting their complexes is more powerful antibacterial agent and other N & S etc. containing compounds are able to enhance the performance of copper soap. The enhanced activity of newly synthesized complexes as compared to the soap can possibly be explained on the basis of presence of donor atoms N and S as well as the structural compatibility with molecular nature of the toxic moiety.23, 24, 25, 26
The activity of copper soap and complexes derived from Neem oil were found in the follow order soap and complexes respectively:-
For CN Soap
Staphylococcus aureus = Coagulase-negative staphylococci ( CoNs ) > Acinetobactor baumanii = Pseudomonas aeruginosa > Micrococcus
For CEB Complex
Staphylococcus aureus > Coagulase-negative staphylococci ( CoNs ) > Acinetobactor baumanii > Pseudomonas aeruginosa = Micrococcus
For CNB Complex
Coagulase-negative staphylococci ( CoNs ) > Staphylococcus aureus > Acinetobactor baumanii = Pseudomonas aeruginosa > Micrococcus
(Table 4, Table 5, Table 6), (Figure 2, Figure 3, Figure 4, Figure 5, Figure 6).
Table 4. Bactericidal data for copper (II) soap and their complexes derived from Neem oil| Concertration (PPM) | 3 * 104 | 1.5 * 104 | .75 * 104 | .375* 104 | SOLVENT |
| CN S.A. S. aureus (cm) | 1.7 | 1.5 | 1.3 | 1 | 0.3 |
| CEB S.A. S. aureus (cm) | 1.8 | 1.7 | 1.5 | 1.3 | 0.3 |
| CNB S. aureus (cm) | 1.7 | 1.5 | 1.3 | 1.1 | 0.3 |
| CN Cons (cm) | 1.7 | 1.5 | 1.2 | 1 | 0.3 |
| CEB Cons (cm) | 1.7 | 1.5 | 1.3 | 1.1 | 0.3 |
| CNB Cons (cm) | 1.8 | 1.6 | 1.4 | 1.2 | 0.3 |
| CN A. baumanii (cm) | 1.6 | 1.4 | 1.2 | 1 | 0.3 |
| CEB A. baumanii (cm) | 1.6 | 1.4 | 1.2 | 1 | 0.3 |
| CNB A. baumanii (cm) | 1.6 | 1.4 | 1.2 | 1 | 0.3 |
| CN P. aeruginosa (cm) | 1.6 | 1.4 | 1.2 | 1 | 0.3 |
| CEB P. aeruginosa (cm) | 1.5 | 1.3 | 1.2 | 1 | 0.3 |
| CNB P. aeruginosa (cm) | 1.6 | 1.4 | 1.2 | 1 | 0.3 |
| CN Micrococcus (cm) | 1.5 | 1.3 | 1.2 | 1 | 0.3 |
| CEB Micrococcus (cm) | 1.5 | 1.3 | 1.1 | 0.9 | 0.3 |
| CNB Micrococcus (cm) | 1.5 | 1.3 | 1.1 | 0.9 | 0.3 |
| Bacteria | Soap / Complex | Group | Count | Sum | Average | Variance | Std. Deviation | Std. Error | Coff. Variance |
| S. aureus | CN | 3* 104 | 3 | 5 | 1.67 | 0.003 | 0.058 | 0.033 | 0.035 |
| 1.5*104 | 3 | 4.4 | 1.47 | 0.003 | 0.058 | 0.033 | 0.040 | ||
| .75*104 | 3 | 3.8 | 1.27 | 0.003 | 0.058 | 0.033 | 0.046 | ||
| .375*104 | 3 | 3.1 | 1.03 | 0.003 | 0.058 | 0.033 | 0.056 | ||
| CEB | 3* 104 | 3 | 5.5 | 1.77 | 0.003 | 0.058 | 0.033 | 0.033 | |
| 1.5*104 | 3 | 5 | 1.67 | 0.003 | 0.058 | 0.033 | 0.035 | ||
| .75*104 | 3 | 4.4 | 1.47 | 0.003 | 0.058 | 0.033 | 0.040 | ||
| .375*104 | 3 | 3.8 | 1.27 | 0.003 | 0.058 | 0.033 | 0.046 | ||
| CNB | 3* 104 | 3 | 5 | 1.67 | 0.003 | 0.058 | 0.033 | 0.035 | |
| 1.5*104 | 3 | 4.4 | 1.47 | 0.003 | 0.058 | 0.033 | 0.039 | ||
| .75*104 | 3 | 3.8 | 1.27 | 0.003 | 0.058 | 0.033 | 0.046 | ||
| .375*104 | 3 | 3.2 | 1.07 | 0.003 | 0.058 | 0.033 | 0.054 | ||
| Cons | CN | 3* 104 | 3 | 5 | 1.67 | 0.003 | 0.058 | 0.033 | 0.035 |
| 1.5*104 | 3 | 4.4 | 1.47 | 0.003 | 0.058 | 0.033 | 0.039 | ||
| .75*104 | 3 | 3.7 | 1.23 | 0.003 | 0.058 | 0.033 | 0.047 | ||
| .375*104 | 3 | 3.1 | 1.03 | 0.003 | 0.058 | 0.033 | 0.056 | ||
| CEB | 3* 104 | 3 | 5 | 1.67 | 0.003 | 0.058 | 0.033 | 0.035 | |
| 1.5*104 | 3 | 4.4 | 1.47 | 0.003 | 0.058 | 0.033 | 0.039 | ||
| .75*104 | 3 | 3.8 | 1.27 | 0.003 | 0.058 | 0.033 | 0.046 | ||
| .375*104 | 3 | 3.2 | 1.07 | 0.003 | 0.058 | 0.033 | 0.054 | ||
| CNB | 3* 104 | 3 | 5.3 | 1.77 | 0.003 | 0.058 | 0.033 | 0.033 | |
| 1.5*104 | 3 | 4.7 | 1.57 | 0.003 | 0.058 | 0.033 | 0.037 | ||
| .75*104 | 3 | 4.1 | 1.37 | 0.003 | 0.058 | 0.033 | 0.042 | ||
| .375*104 | 3 | 3.5 | 1.17 | 0.003 | 0.058 | 0.033 | 0.049 |
| Bacteria | Soap / Complex | SS | df | MS | F | P-value | F crit |
| S. aureus | CN | 0.66 | 3 | 0.22 | 66.25 | 5.43E-06 | 4.066 |
| CEB | 0.44 | 3 | 0.15 | 44.25 | 2.51E-05 | 4.066 | |
| CNB | 0.6 | 3 | 0.2 | 60 | 7.93E-06 | 4.066 | |
| Cons | CN | 0.68 | 3 | 0.23 | 68.33 | 4.82E-06 | 4.066 |
| CEB | 0.6 | 3 | 0.2 | 60 | 7.93E-06 | 4.066 | |
| CNB | 0.6 | 3 | 0.2 | 60 | 7.93E-06 | 4.066 | |
| A. baumanii | CN | 0.6 | 3 | 0.2 | 60 | 7.93E-06 | 4.066 |
| CEB | 0.6 | 3 | 0.2 | 60 | 7.93E-06 | 4.066 | |
| CNB | 0.6 | 3 | 0.2 | 60 | 7.93E-06 | 4.066 | |
| P. aeruginosa | CN | 0.6 | 3 | 0.2 | 60 | 7.93E-06 | 4.066 |
| CEB | 0.39 | 3 | 0.13 | 39 | 4.02E-05 | 4.066 | |
| CNB | 0.6 | 3 | 0.2 | 60 | 7.93E-06 | 4.066 | |
| Micrococcus | CN | 0.39 | 3 | 0.13 | 39 | 4.02E-05 | 4.066 |
| CEB | 0.6 | 3 | 0.2 | 60 | 7.93E-06 | 4.066 | |
| CNB | 0.6 | 3 | 0.2 | 60 | 7.93E-06 | 4.066 |
Figure 2.Zone of Copper Neem Soap For Staphylococcus aureus
Figure 3.Zone of Copper Neem Soap 2-amino -6-ethoxy Complex for Staphylococcus aureus
Figure 4.Zone of Copper Neem Soap 2-amino -6-nitro Complex for Coagulase-negative staphylococci (CoNs)
Figure 5.The Plot data for copper (II) soap and their complexes derived from Neem oil
Conclusions
Copper neem soap and its complex has been synthesized and evaluated for their anti-microbial activity against Gram-positive and Gram-negative bacteria. Many of pharmaceuticals and related chemicals, however, are toxic to humans and hard to degrade within the environment. Biomedical and bio-degradable products will be in the near future largest application of antimicrobial studies, which must be the area of interest for the scientists to explore the new drug formulation.
Acknowledgements
The authors are thankful to UGC for JRF and Principal and Head of Department (SPC Govt. College, Ajmer) for laboratory facilities. We are also thankful to Dr. P.K. Khatri (Head of Department Microbiology, Dr. S.N. Medical, Jodhpur) Dr. Archana Bora and Dr. R.S. Parihar for their kind cooperation.
References
- 1.Shay G. (1993) Diesel fuel from vegetable oil: status and opportunities. , Biomass Bio-energy 4, 227-242.
- 2.Arjun B C, Watts K C, Islam M R. (2008) Waste cooking oil as an alternate feedstock for biodiesel production. , Energies 1, 3-8.
- 3.FA Liauw MY Natan, Widiyanti P, Ikasari D, Indraswati N, Soetaredjo F E. (2008) Extraction of neem oil (AzadirachtaindicaA. Juss) using N-Hexane and Ethanol: studies of oil quality, kinetic and thermodynamic.ARPN. , Journal of Engineering and Applied 3(3), 49-54.
- 4.P C Sharma, Sinhmar A, Sharma A, Rajak H, D P Pathak. (2013) and Enzyme. , J. Inhib. Med. Chem 28(2), 240-266.
- 6.Sharma R, Saxena M, Sharma N. (2012) Synthesis, spectroscopic and fungicidal studies of copper soaps derived from mustard and soyabean oils and their urea complexes.Int. , J Chem Sci 10(1), 143-149.
- 7.Heda L C, Mathur N, Saxena P, Ahmed I. (2009) Physical Properties of Copper (II) Soap complexes in Binary Solvent Mixture. , Asian Journal of Chemistry 21(1), 57-62.
- 8.Vernozy-Rozand C, Mazuy C, Meugnier H, Bes M, Lasne Y et al. (2000) Staphylococcus fleurettii sp. nov., isolated from goat's milk cheeses.Int J SystEvolMicrobiol.50: Pt. 4, 1521-1527.
- 9.Rupp M E, Archer G L. (1994) Coagulase-negative staphylococci: pathogens associated with medical progress.Clin Infect Dis. 19, 231-243.
- 10.S G Joshi, G M Litake, M G Satpute, N V Telang, V S Ghole et al. (2006) Clinical and demographic features of infections caused byAcinetobacterspecies. , Indian J. Med Sci 60(9), 357-360.
- 11.Fricks-Lima J, Hendrickson C M, Allgaier A, Zhuo H, Wiener-Kronish J P et al. (2012) Differences in biofilm formation and antimicrobial resistance ofPseudomonas aeruginosaisolated from airways of mechanically ventilated patients and cystic fibrosis patients.Int. , J Antimicrob. Agents 37, 309-315.
- 12.K H Schleifer, W E Kloos, Moore A. (1972) Taxonomic status ofMicrococcus luteus(Schroeter 1872)Cohn 1872:correlation between peptidoglycan type and genetic compatibility. , Int. J. Syst. Bacteriol 22, 224-227.
- 13.Basset J, Denney R C, Jeffery G H, Mendham J, Vogels. (1985) . Textbook of Quantitative Inorganic Analysis.4thed.Longman,London .
- 14.J R Riddick, W B Bunger. (1970) Organic Solvents: Physical Properties and Methods of Purification. Wiley Interscience. , New York
- 15.F D Gunstone. (1958) An Introduction to the Chemistry of Fats and Fatty Acids. Chapman and Hall Ltd.,London.
- 18.Cassina M. (2014) First-trimester exposure to metformin and risk of birth defects: A systematic review and meta-analysis”. Human Reproduction Update.20(5):. 656-669.
- 19.Lindsey A Torre, Trabert Britton, Carol E Desantis, Kimberly D Miller, Samimi G et al. (2018) Ovarian cancer statistics.
- 22.Silverstein Bassler, Morrill. (1991) Spectrometric Identification of Organic Compounds. 5thed John Wiley and sons. , Inc 90-95.
- 24.Santulli L, Coppola A, Balestrini S, Striano S. (2016) The challenges of treating epilepsy with 25 antiepileptic drugs.PharmacolRes. 107-211.
Cited by (3)
- 1.Sukhadia Vandana, Sharma Rashmi, Meena Asha, 2020, Photocatalytic Degradation and Antibacterial Study of Copper(II) Mustard Thiourea Complex, Current Physical Chemistry, 10(3), 229, 10.2174/1877946810666200221122053
- 2.Meena Asha, Sharma Rashmi, Sukhadia Vandana, 2020, Synthesis and Characterization of Chemical Structures, Thermal Decomposition and Biological Properties of Novel Copper (II) Bio- Based Surfactants, Current Physical Chemistry, 10(3), 213, 10.2174/1877946810666200116091321
- 3.de Oliveira Viana Jéssika, Monteiro Alex France Messias, Filho José Maria Barbosa, Scotti Luciana, Scotti Marcus Tullius, 2020, The Azoles in Pharmacochemistry: Perspectives on the Synthesis of New Compounds and Chemoinformatic Contributions, Current Pharmaceutical Design, 25(44), 4702, 10.2174/1381612825666191125090700

